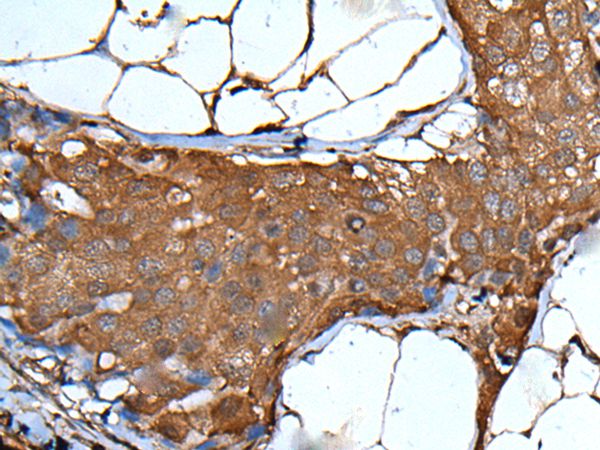
Anti-VSIG1 Antibody

VSIG1 Antibody
LS-C817598
ApplicationsImmunoHistoChemistry, ImmunoHistoChemistry Paraffin
Product group Antibodies
TargetVSIG1
Overview
- SupplierLifeSpan BioSciences
- Product NameVSIG1 Antibody
- Delivery Days Customer14
- Application Supplier NoteApplications should be user optimized.
- ApplicationsImmunoHistoChemistry, ImmunoHistoChemistry Paraffin
- Applications SupplierIHC-P (1:500 - 1:3000) Applications should be user optimized.
- CertificationResearch Use Only
- ClonalityPolyclonal
- ConjugateUnconjugated
- Estimated Purity...
- Gene ID340547
- Target nameVSIG1
- Target descriptionV-set and immunoglobulin domain containing 1
- Target synonyms1700062D20Rik, GPA34, dJ889N15.1, V-set and immunoglobulin domain-containing protein 1, cell surface A33 antigen, glycoprotein A34
- HostRabbit
- IsotypeIgG
- Storage Instruction-20°C or -80°C,2°C to 8°C
- UNSPSC12352203